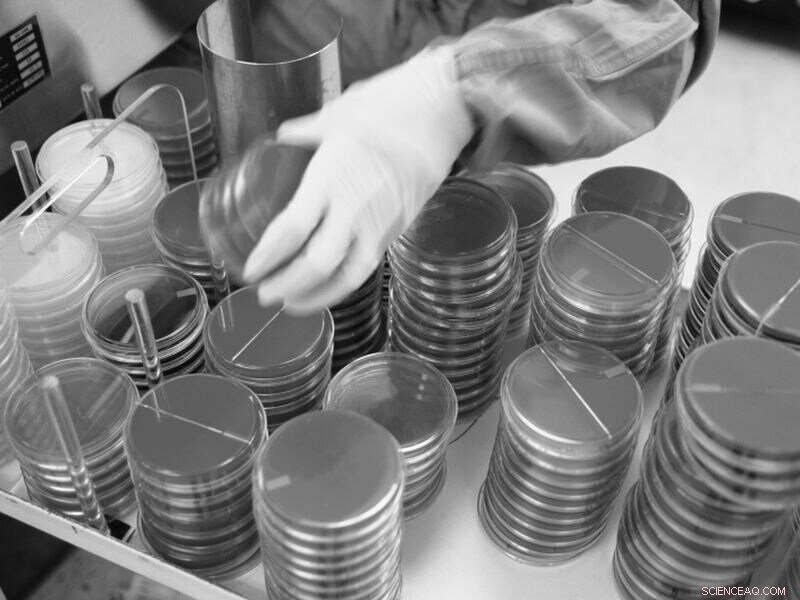
Did Columbus Truly Bring Syphilis to Europe? New Research Challenges the Myth

Explorer Christopher Columbus, long blamed for bringing syphilis to Europe from the New World, may have gotten a bad rap, new research suggests.
Researchers have uncovered traces of the bacteria that causes syphilis in archaeological human remains from Finland, Estonia and the Netherlands that predate Columbus' explorations. The findings were recently published in the journal Current Biology.
"It seems that the first known syphilis breakout cannot be solely attributed to Columbus' voyages to America," study author Verena Schünemann, a professor of paleogenetics at the University of Zurich in Switzerland, said in a university news release.
Syphilis, a sexually transmitted disease that is now easily curable if caught early, took hold in Europe during the late 15th century and killed millions over the following two centuries.
Researchers also found evidence of related bacterial strains in the historical remains—one that causes a disease called yaws, which still exists today in tropical and subtropical regions, and another, previously unknown, pathogen.
By analyzing the bacteria's genetic code, researchers found that the predecessor of all modern syphilis likely evolved between the 12th and 16th centuries.
But the newly discovered diversity among the family of bacteria that causes syphilis may indicate that the disease originated or developed in Europe, potentially dispelling the long-held theory that Columbus and his sailors triggered the outbreak after one of four voyages between 1492 and 1502, researchers said.
Although syphilis is treatable when detected early, it is still a rapidly spreading disease. The most recent World Health Organization data estimates that there were 6 million new cases of syphilis worldwide in 2016.
Copyright © 2020 HealthDay. All rights reserved.